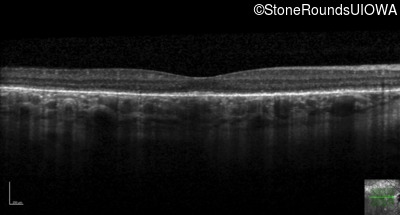
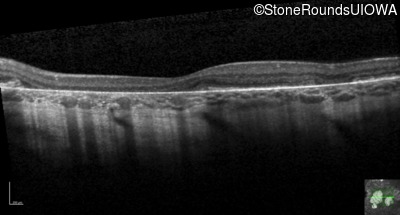
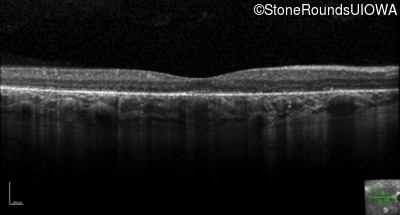
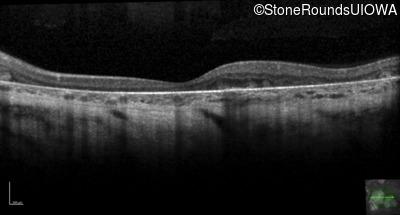

Case
SR623
Student Mode
MIDD (IID1a)
Female
Female
Hidden
SR623
Student Mode
MIDD (IID1a)
Female
Female
History
This 31 year old woman had subtle macular abnormalities discovered incidentally earlier that year. Her medical history at the time was unremarkable except for gestational diabetes during her most recent pregnancy. Five years later she was diagnosed with type 2 diabetes managed with oral medication. Two years later she developed sufficient hearing loss that hearing aids were required. Her acuity remained 20/20 OU at that time.
| Age at visit: 33 years (Visit 2) |
| OD | OS | ||
|---|---|---|---|
| Age at visit: 36 years |
| OD | OS | ||
|---|---|---|---|
| OD | OS | ||
|---|---|---|---|
| OD | OS | ||
|---|---|---|---|
| Age at visit: 41 years |
| OD | OS | ||
|---|---|---|---|
| OD | |||
|---|---|---|---|
| OD | OS | ||
|---|---|---|---|
| Age at visit: 46 years |
| OD | OS | ||
|---|---|---|---|
| OD | OS | ||
|---|---|---|---|
| OD | OS | ||
|---|---|---|---|
| OD | OS | ||
|---|---|---|---|